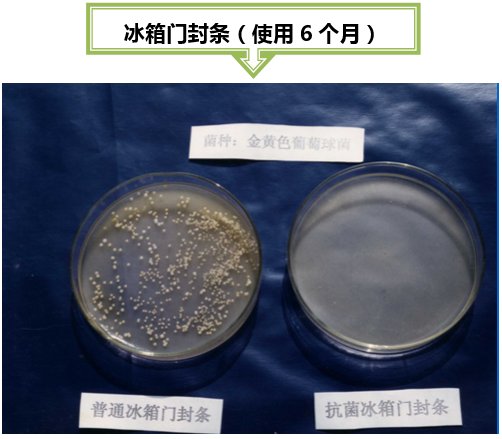

在開始今天的主題之前,我們先來看看某款抗菌冰箱,它有哪些抗菌零部件呢?


眼見為實,見證奇跡的時刻到了!

以銀離子為例,我們來看一下抗菌過程是如何發(fā)生的。

目前,抗菌塑料主要通過在普通塑料中添加少量抗菌劑的方法獲得。

由于無機抗菌劑具有這樣的許多優(yōu)點及塑料制品要求的成型條件通常在200℃左右的高溫,且要經(jīng)受強烈的機械剪切加工。因此,在塑料制品中使用無機 抗菌劑要比使用有機抗菌劑好得多。


抗菌塑料是如何制造出來的?

如何判斷抗菌塑料的抗菌性?
抗菌性是衡量抗菌性能的重要指標(biāo)。
滅菌:殺滅物體中所有微生物(包括病原菌和非病原菌)的繁殖體和芽胞的方法或作用叫做滅菌。
消毒:指殺死病原菌的方法或作用。具有消毒作用的藥物稱為消毒劑。一般消毒劑在常用的濃度下只對細(xì)菌的繁殖體有效,對于芽胞則無殺害作用。
抗菌:防止或抑制微生物生長的方法或作用叫做抑菌或防腐。
用于抑菌的藥物,稱為抑菌劑或防腐劑。許多藥品在低濃度時只有抑菌作用,濃度增大或作用時間長時,可起殺菌作用,殺菌作用和抑菌作用總稱為抗菌作用。
抗菌塑料幾乎可以應(yīng)用于生活的方方面面。


抗菌塑料發(fā)展過程中遇到哪些問題?

抗菌塑料的發(fā)展前景如何?
抗菌塑料的開發(fā)和應(yīng)用為保護人類健康樹起了一道綠色屏障,對于改善人類生存環(huán)境,減少疾病,保護全民健康,具有十分重要的意義。正因為抗菌塑料及其制品為提高全民生活質(zhì)量創(chuàng)造了良好條件,所以抗菌家電和日用品一經(jīng)投放市場就受到廣大消費者的青睞。
據(jù)預(yù)測,在家電和日用品中得到應(yīng)用后,抗菌塑料發(fā)展的第二階段市場將主要是抗菌建材和室內(nèi)裝飾材料。高檔轎車的內(nèi)飾件也將越來越多地采用抗菌材料,如日產(chǎn)轎車的方向盤、內(nèi)飾絨 布、座位、把手等均已實現(xiàn)抗菌化。
不難預(yù)測,未來的產(chǎn)品將向著性能優(yōu)異、價格低廉、用量少、抗菌性能高、抗菌、防霉并兼具抗紫外、防靜電等多功能復(fù)合的方向發(fā)展。隨著人們對抗菌塑科研究開發(fā)的深入和人們的衛(wèi)生保健意識增強,抗菌塑料的應(yīng)用前景十分廣闊。

















